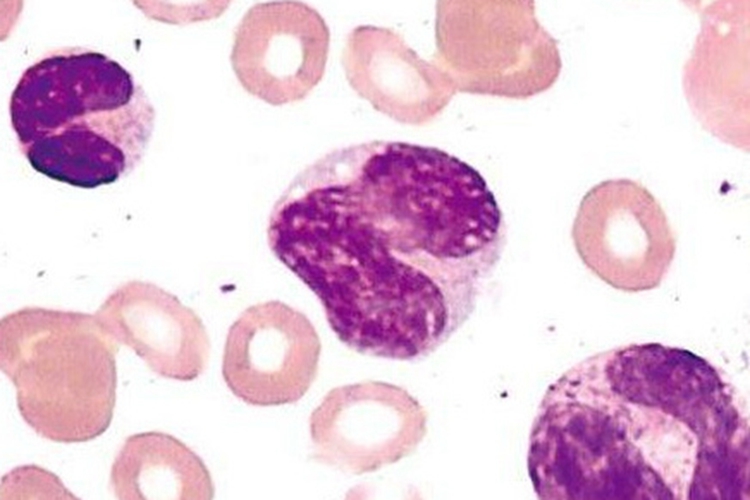
中性粒细胞图
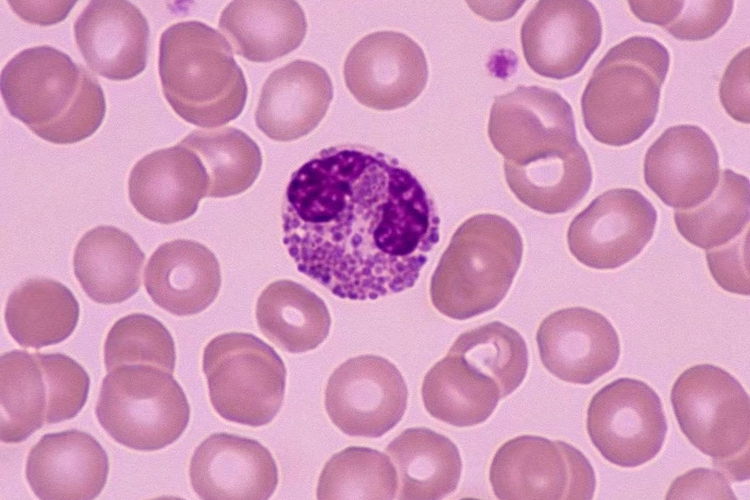
嗜酸性粒细胞图
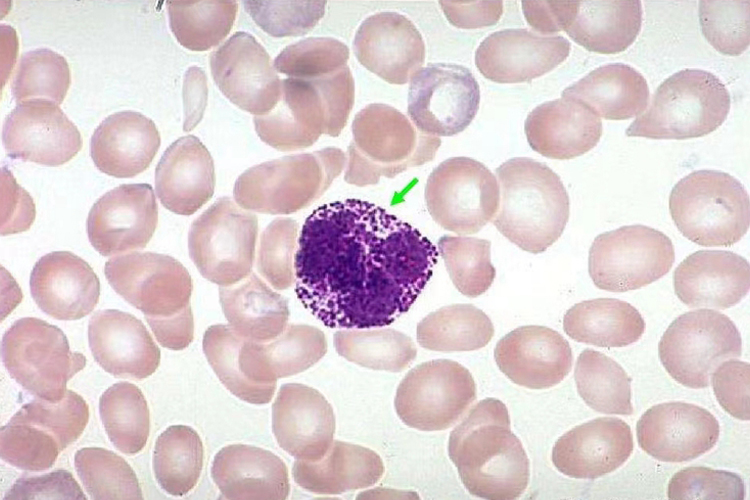
嗜碱性粒细胞图
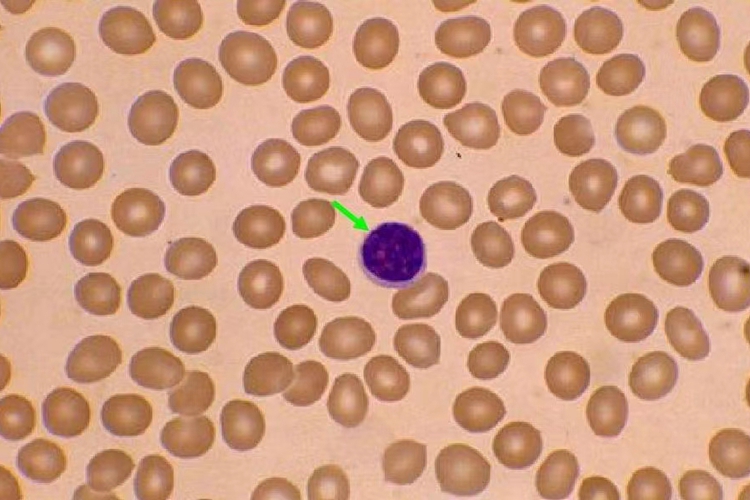
淋巴细胞图

概述
白细胞为一种无色、有核的血细胞,在血液中一般呈球形。
白细胞可分为中性粒细胞、嗜酸性粒细胞、嗜碱性粒细胞、单核细胞以及淋巴细胞五种。
形态
白细胞是一种血细胞,分为五种,分别为中性粒细胞、嗜酸性粒细胞、嗜碱性粒细胞、单核细胞以及淋巴细胞,各自形态有一定差异。
中性粒细胞
是数量最多的白细胞,细胞直径10-12μm。核呈深染的弯曲杆状或分叶状,分叶核一般为2-5叶,叶间有纤细的缩窄部相连。细胞质呈极浅的粉红色,含有许多细小颗粒,其中浅紫色的为嗜天青颗粒,浅红色的为特殊颗粒。
嗜酸性粒细胞
直径为10-15μm,核多为2叶,胞质内充满粗大的鲜红色嗜酸性颗粒,直径0.5-1.0μm。电镜下可见颗粒内基质中有长方形结晶体。
嗜碱性粒细胞
是数量最少的白细胞,细胞直径10-12μm,核分叶,或呈S形或不规则形,着色较浅。胞质中含有嗜碱性颗粒,大小不等,分布不均,染成蓝紫色,可将核掩盖。
单核细胞
是体积最大的白细胞,直径为14-20μm,核呈肾形、马蹄铁形或扭曲折叠的不规则形,染色质颗粒细而松散,故着色较浅。胞质丰富,因弱嗜酸性而呈蓝灰色,内含许多细小的淡紫色嗜天青颗粒。

淋巴细胞
血液中的淋巴细胞大部分为直径6-8μm的小淋巴细胞,小部分为直径9-12μm的中淋巴细胞。在淋巴组织中还有直径13- 20μm的大淋巴细胞,但不存在于血液中。小淋巴细胞的核为圆形,一侧常有浅凹,染色质浓密呈块状,着色深。中淋巴细胞的核染色质略稀疏,着色略浅,有的可见核仁。淋巴细胞的胞质为嗜碱性,呈蔚蓝色。小淋巴细胞的胞质很少,在核周形成很薄的一圈,中淋巴细胞胞质较多;胞质中可含嗜天青颗粒。
功能
各自类型的白细胞具有不同的功能,如下:
中性粒细胞:可吞噬外来微生物以及吞噬机体自身的坏死组织和衰老的红细胞。
嗜酸性粒细胞:可以抑制过敏反应,抑制嗜碱性粒细胞和肥大细胞合成与释放生物活性物质,从而抑制其在过敏反应中的作用;还可以参与对蠕虫的免疫反应。
嗜碱性粒细胞:可以释放肝素、组胺、过敏性慢反应物质等。肝素具有抗凝血功能;组胺和过敏性慢反应物质可引起过敏反应。
单核细胞:可以吞噬较大的颗粒,还可参与免疫反应。
淋巴细胞:淋巴细胞参与机体的特异性免疫反应,是构成机体防御系统的重要组成部分。
参考文献
[1]杨五彪主编.正常人体功能[M].天津.天津科学技术出版社2020.160.
[2]李继承,曾园山.组织学与胚胎学.第9版[M].北京.人民卫生出版社.2018.40-41.
[3]赵学纲主编;潘玉玲,王雯,金晖副主编;刘德要,郑彦立,孙璐编委.实用人体学下大字版[M].北京.中国盲文出版社.2020.353-354.
